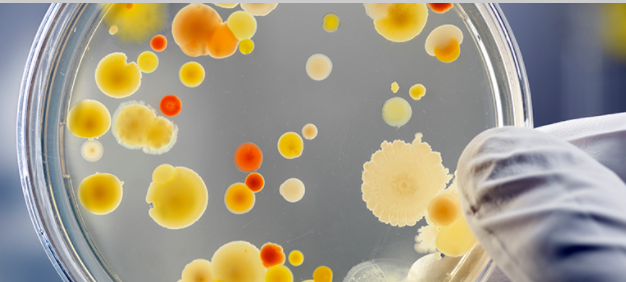

La resistència antimicrobiana i el projecte SAFE
En el marc dels Juliols de la UB podeu gaudir d’aquest curs de formació per a docents de secundària. Es treballaran continguts de microbiologia per a poder-los aplicar directament als instituts. Més informació i inscripcions
En el marc dels Juliols de la UB podeu gaudir d’aquest curs de formació per a docents de secundària. Es treballaran continguts de microbiologia per a poder-los aplicar directament als instituts. Més informació i inscripcions





















